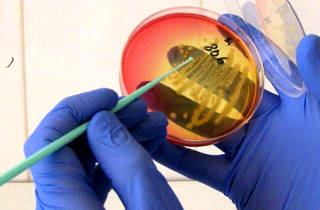

Механизм развития заболевания
Причины воспаления слизистых оболочек носовых пазух разнообразны. Наиболее часто встречается этмоидит у детей дошкольного и младшего школьного возраста. Это связано с анатомическими особенностями черепа: у малышей придаточные пазухи носа расположены ближе друг к другу, чем у взрослых. Кроме того, дети с еще не полностью сформировавшимся иммунитетом страдают от простудных и респираторных заболеваний в три раза чаще, в среднем 5-6 раз в год.
Придаточные пазухи носа — это полые структуры в костях черепа, выстланные слизистыми оболочками. Существует четыре основных типа этих пазух:
- фронтальные — симметрично расположены в центре лба над внутренними уголками бровей;
- верхнечелюстные — находятся под глазницами, по обе стороны от крыльев носа, соседствуя с костями верхней челюсти;
- решетчатый лабиринт — ячеистая симметричная структура, расположенная по обе стороны от средней части переносицы и соприкасающаяся с внутренней частью глазницы;
- клиновидная пазуха — находится в одной из костей, формирующих основание черепа.
Каждая из пазух имеет свое название при воспалительных процессах: фронтит (фронтальные или лобные), гайморит (верхнечелюстные), этмоидит (решетчатый лабиринт) и сфеноидит (клиновидная). Это важно знать, так как у детей часто одновременно поражаются соседние пазухи, что может привести к диагнозу, например, фронтоэтмоидит.
В 90% случаев острый этмоидит возникает из-за попадания патогенных бактерий в дыхательные пути. Инфекция из носовой полости легко проникает в придаточные пазухи, вызывая воспаление эпителиальных клеток. В результате слизистые оболочки опухают и отекают. Узкий проход, соединяющий пазуху с носовой полостью, может частично или полностью перекрываться, что нарушает нормальную циркуляцию воздуха в ячейках решетчатого лабиринта.
Это создает благоприятные условия для размножения анаэробных бактерий и накопления гнойной слизи, которая не имеет выхода. Жидкость оказывает давление на воспаленные слизистые и раздражает их чувствительные нервные окончания, вызывая интенсивные болевые ощущения.
При отсутствии должного лечения заболевание быстро распространяется на соседние пазухи носа и может приводить к образованию метастатических гнойных очагов в других органах.
Врачи отмечают, что этмоидит у детей часто проявляется в виде насморка, затрудненного дыхания, головной боли и повышенной температуры. Симптомы могут варьироваться от легкой заложенности носа до более серьезных проявлений, таких как отек вокруг глаз и общая слабость. Важно своевременно обратиться к специалисту, так как неправильное лечение может привести к осложнениям.
Лечение этмоидита обычно включает назначение антибиотиков, если заболевание вызвано бактериальной инфекцией, а также применение противовоспалительных средств и промывание носа солевыми растворами. Врач может рекомендовать физиотерапию для улучшения состояния. Важно, чтобы родители следили за состоянием ребенка и не занимались самолечением, так как это может усугубить ситуацию. Регулярные осмотры у отоларинголога помогут избежать рецидивов и обеспечить правильное лечение.

Основные причины
Хотя острый этмоидит чаще всего встречается у детей как осложнение вирусных респираторных инфекций, существуют и другие факторы, способствующие его развитию. У новорожденных и младенцев он может возникнуть из-за внутренней инфекции, особенно на фоне сепсиса, когда инфекция проникает в решетчатый лабиринт через кровеносную систему.
Наиболее распространенные причины развития этмоидита у детей:
- Частые простуды и вирусные инфекции ослабляют иммунную систему, создавая условия для размножения патогенных микроорганизмов.
- Хронические заболевания носовых пазух (гайморит, фронтит) — воспалительные процессы легко распространяются из одной пазухи в другую.
- Наличие мелких инородных тел в носу, которые могут незначительно затруднять дыхание, но нарушают нормальную циркуляцию воздуха и затрудняют отток слизи.
- Травмы носа могут привести к сужению носовых проходов или искривлению носовой перегородки.
- Некоторые медикаменты, при неправильном или неконтролируемом применении, могут вызывать отек слизистой носа.
- Сильные аллергические реакции приводят к отечности и полной закупорке естественного прохода в решетчатый лабиринт.
- Увеличение аденоидов сжимает слизистые, нарушая приток кислорода и нормальную циркуляцию воздуха.
Определение основной причины заболевания имеет большое значение и должно быть выполнено как можно скорее. В противном случае даже качественное лечение может оказаться неэффективным, и болезнь перейдет в хроническую стадию, что может привести к серьезным осложнениям.
| Симптом | Возможная причина (в контексте этмоидита) | Рекомендации по лечению/облегчению симптомов |
|---|---|---|
| Заложенность носа | Воспаление слизистой оболочки решетчатой кости | Сосудосуживающие капли/спреи (кратковременно!), промывание носа солевым раствором, увлажнение воздуха |
| Гнойные выделения из носа | Нагноение в пазухах носа | Антибиотики (по назначению врача), промывание носа |
| Головная боль | Давление, вызванное воспалением и отеком в пазухах | Анальгетики (по назначению врача), отдых |
| Кашель | Стекание слизи по задней стенке глотки | Отхаркивающие средства (по назначению врача), обильное питье |
| Лихорадка | Инфекционный процесс | Жаропонижающие средства (по назначению врача), обильное питье, постельный режим |
| Ухудшение обоняния/вкуса | Воспаление слизистой оболочки, блокирующее рецепторы | Лечение основного заболевания, промывание носа |
| Боль в области глазниц | Распространение воспаления | Холодные компрессы, анальгетики (по назначению врача) |
| Слезотечение | Раздражение слизистой оболочки | Промывание глаз, искусственные слезы |
| Усталость, вялость | Общее недомогание, вызванное инфекцией | Постельный режим, обильное питье |
Признаки болезни
Диагностика этмоидита у детей младшего возраста представляет собой серьезную проблему. Основной признак этого заболевания — четко локализованные болевые ощущения, которые могут возникать с одной или обеих сторон от средней части носа и иногда иррадиировать в глаз. Малыши не могут точно описать свои ощущения. Поэтому на приеме должен быть опытный педиатр, который проведет тщательную пальпацию черепа. Ребенок сможет спокойно перенести эту процедуру, начав плакать только при нажатии на болезненные участки.
Часто на остром этапе начинают лечить ОРВИ или грипп, в то время как этмоидит продолжает развиваться. К моменту его выявления могут уже наблюдаться осложнения.
Чтобы избежать такой ситуации, следует обратиться к врачу, если у ребенка одновременно наблюдаются три или более из следующих симптомов:
- постоянный беспричинный плач;
- частое мотание головой;
- затрудненное дыхание через одну ноздрю;
- дыхание исключительно ртом;
- периодические гнойные выделения из носа;
- нарушения сна, как днем, так и ночью;
- вялость и быстрая утомляемость;
- потеря интереса к любимым игрушкам;
- снижение аппетита и потеря веса;
- субфебрильная температура тела;
- резкое повышение температуры;
- периодический непродуктивный кашель.
Некоторые из этих симптомов могут также свидетельствовать о других заболеваниях. Однако наличие указанных признаков указывает на серьезные проблемы в организме ребенка, которые необходимо выяснить как можно скорее.
Этмоидит у детей — это воспаление решетчатой кости, которое может вызывать серьезные дискомфорты. Родители часто отмечают, что у ребенка появляются симптомы, такие как заложенность носа, выделения из носа, головные боли и повышенная температура. Иногда дети жалуются на боль в области глаз и лица. Важно не игнорировать эти признаки, так как запущенный этмоидит может привести к осложнениям.
Лечение обычно включает назначение антибиотиков, если причина заболевания бактериальная. Также могут быть рекомендованы противовоспалительные препараты и промывания носа солевыми растворами. В некоторых случаях требуется консультация отоларинголога для более детального обследования. Родители должны следить за состоянием ребенка и при ухудшении симптомов обращаться к врачу, чтобы избежать серьезных последствий.

Методы диагностики
Первичный осмотр малыша всегда проводит педиатр. Однако для точной диагностики этмоидита этого может быть недостаточно. Рекомендуется обратиться к отоларингологу, если такой вариант не предложил врач.
Специалист располагает необходимыми инструментами для детального обследования ротовой и носовой полости ребенка и обладает знаниями о специфике респираторных заболеваний.
Окончательный диагноз устанавливается на основе аппаратных методов диагностики и клинических лабораторных исследований:
- Анализ крови — помогает определить наличие активного воспалительного процесса и его интенсивность.
- Бактериальный посев слизи — позволяет выявить патогенные микроорганизмы и оценить их чувствительность к медикаментам.
- Эндоскопическое исследование — дает возможность тщательно осмотреть состояние ячеек лабиринта и проверить их на наличие полипов и других образований.
- Рентгеновские снимки — выполняются в нескольких проекциях, показывают поврежденные ячейки лабиринта и наличие воспалительных процессов в других придаточных пазухах.
- Компьютерная томография — применяется для очень маленьких детей и в случаях, когда другие методы диагностики затруднены. Это наиболее информативный способ обследования.
Лечение назначается на основании результатов обследования. Если состояние ребенка удовлетворительное, его не нужно помещать в стационар. Достаточно соблюдать постельный режим, внести изменения в рацион и строго следовать рекомендациям врача. В случае значительного скопления гноя и сильного распространения инфекции может быть рекомендована госпитализация.
Способы лечения
Внимание, уважаемые родители! Лечение этмоидита народными средствами неэффективно и особенно опасно для детей. Это может привести к потере времени, осложнениям или переходу заболевания в хроническую стадию. Если вы заботитесь о здоровье вашего ребенка, обязательно обращайтесь к врачу и следуйте его рекомендациям. Это обеспечит быстрое и полное выздоровление.
Курс интенсивной терапии основывается на комплексном подходе. Он включает медикаментозное лечение, промывание носа, укрепление иммунной системы и физиотерапевтические процедуры на стадии выздоровления. Такой метод позволяет быстро и эффективно устранить как причины заболевания, так и его симптомы.
Исключение составляет лечение аллергического этмоидального ринита, который возникает у детей, предрасположенных к частым и сильным аллергическим реакциям. В этом случае важно выявить и, по возможности, устранить аллергены. Пока это происходит, совместно с аллергологом подберите подходящий антигистаминный препарат для ребенка.
Лечение инфекционного этмоидита, скорее всего, потребует применения антибиотиков для полного уничтожения патогенных микроорганизмов, вызывающих воспаление. Антибиотики подбираются индивидуально, а дозировки должны строго соблюдаться.
В процессе лечения могут быть использованы:
- жаропонижающие средства – для снижения температуры выше 38°C;
- противовоспалительные препараты – для устранения боли и купирования воспалительного процесса;
- противовирусные средства – если заболевание находится в острой фазе и вызвано вирусами;
- сосудосуживающие препараты – для быстрого снятия отечности и восстановления дыхания;
- антигистаминные средства – для профилактики аллергии на антибиотики и устранения отека;
- муколитики – для разжижения густой слизи и ее активного отхождения;
- иммуностимуляторы – для повышения защитных сил организма.
Назначение конкретных препаратов должен осуществлять лечащий врач. Самостоятельные изменения в курсе лечения недопустимы.
Необходимо несколько раз в день промывать нос ребенка солевым раствором или специальными средствами, такими как «Аквамарис», «Долфин» и другие. Масляный раствор хлорофиллипта обладает хорошим антисептическим эффектом. Также можно использовать «Пиносол», который содержит экстракты растений с антибактериальными и антисептическими свойствами.
Важно обеспечить ребенку щадящий режим дня, ограничить контакты с другими детьми и активные игры.
Питание должно быть полноценным и разнообразным, с большим количеством свежих фруктов и овощей. Если это невозможно, попросите врача порекомендовать хороший детский мультивитаминный комплекс.
При правильно подобранном лечении, отсутствии осложнений и соблюдении всех рекомендаций врача, значительное улучшение состояния может наступить уже на 3-4 день, а полное выздоровление – за 7-10 дней. Осложненная форма может потребовать 2-3 недели терапии и даже хирургического вмешательства, поэтому не стоит допускать ее развития.

Вопрос-ответ
Какие симптомы этмоидита у детей?
Симптомы этмоидита у детей могут включать заложенность носа, выделения из носа (часто гнойные), головную боль, боль в области глаз и лба, повышенную температуру, а также возможное ухудшение общего состояния. В некоторых случаях может наблюдаться отек вокруг глаз и чувствительность при нажатии на область носа и лба.
Можно ли вылечить этмоидит без операции?
Как и другие синуситы, этмоидит может быть очень опасен, в первую очередь в связи с осложнениями, среди которых менингит и абсцесс головного мозга. Самостоятельно диагностировать и составить лечение этмоидита невозможно.
Каким антибиотиком лечат этмоидит?
Антибиотики при остром гнойном этмоидите – цефазолин, цефотаксим, амоксиклав, амоксициллин. Кроме того, назначается противовоспалительная терапия, сосудосуживающие капли, иммуномодуляторы и витамины. Хорошим дополнением станет промывание придаточных пазух и физиотерапия.
Какие сопли при этмоидите?
Основные симптомы: головная боль, усиливающаяся при наклоне головы вперёд. Заложенность носа, чаще односторонняя, но может быть и с обеих сторон. Выделения из носа — слизистые или гнойные.
Советы
СОВЕТ №1
Обратите внимание на симптомы: если у вашего ребенка наблюдаются затрудненное дыхание, выделения из носа с неприятным запахом, головные боли или высокая температура, немедленно обратитесь к врачу. Эти признаки могут указывать на этмоидит и требуют профессиональной оценки.
СОВЕТ №2
Следите за гигиеной носа: регулярное промывание носовых ходов солевыми растворами может помочь предотвратить развитие этмоидита, особенно в период простуд и аллергий. Это поможет удалить слизь и бактерии, способствующие воспалению.
СОВЕТ №3
Не занимайтесь самолечением: при подозрении на этмоидит важно не использовать антибиотики без назначения врача. Неправильное лечение может привести к осложнениям. Всегда консультируйтесь с педиатром или отоларингологом для получения правильной диагностики и лечения.
СОВЕТ №4
Обратите внимание на общее состояние ребенка: поддерживайте его иммунитет, обеспечивая сбалансированное питание, достаточное количество жидкости и полноценный сон. Это поможет организму лучше справляться с инфекциями и снизит риск развития этмоидита.